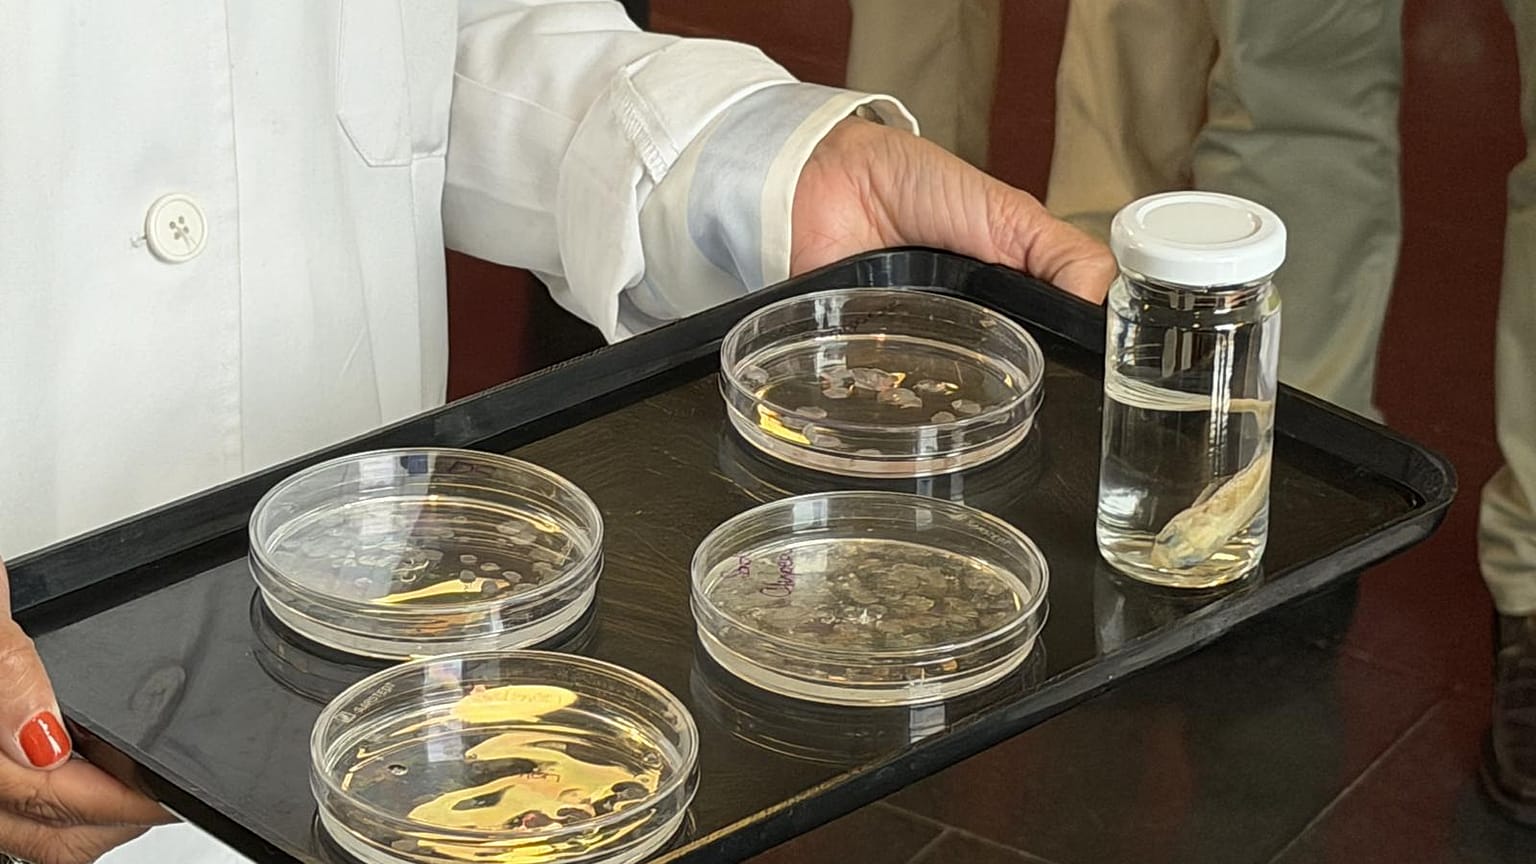
Δείγματα των κλιμάκων που χρησιμοποιούνται για την αποκατάσταση του κερατοειδούς.

Ερευνητές του Πανεπιστημίου της Γρανάδας ανέπτυξαν εμφυτεύματα κερατοειδούς από λέπια ψαριών με πολλά υποσχόμενα αποτελέσματα στο εργαστήριο και σε ζώα
Τα λέπια των ψαριών συνήθως καταλήγουν στον κάδο απορριμμάτων. Στα εργαστήρια του Τμήματος Ιστολογίας της Ιατρικής Σχολής του Πανεπιστημίου της Γρανάδας, ωστόσο, εξετάζουν εδώ και αρκετό καιρό αυτό το απόβλητο με άλλο μάτι. Το αποτέλεσμα είναι ένα βιοσυμβατό, ανθεκτικό και διαφανές εμφύτευμα κερατοειδούς που λαμβάνεται από τα λέπια του κυπρίνου και άλλων ψαριών ευρείας κατανάλωσης.
 ΔΙΑΦΉΜΙΣΗ
ΔΙΑΦΉΜΙΣΗ
 ΔΙΑΦΉΜΙΣΗ
ΔΙΑΦΉΜΙΣΗ
Ο κερατοειδής είναι το διαφανές στρώμα που καλύπτει το μπροστινό μέρος του ματιού και εξυπηρετεί μια ουσιαστική οπτική λειτουργία. Όταν νοσεί σοβαρά, αναγεννάται ελάχιστα και δεν έχει άμεση αιμάτωση, γεγονός που περιπλέκει οποιαδήποτε θεραπεία. Σε πολλές περιπτώσεις, η μόνη διέξοδος είναι η μεταμόσχευση από δότη.
Το πρόβλημα είναι γνωστό: οι λίστες αναμονής είναι μεγάλες και η διαθεσιμότητα υγιούς ιστού είναι περιορισμένη. "Είναι απαραίτητο να αναπτυχθούν νέες αποτελεσματικές μέθοδοι αναγέννησης που δεν εξαρτώνται από τη δωρεά οργάνων", λέει ο Miguel Alaminos, καθηγητής Ιστολογίας στο UGR και ένας από τους συγγραφείς της μελέτης.
Η μελέτη, που δημοσιεύεται στο περιοδικό "Materials & Design", περιγράφει πώς η εξαντλητική ανάλυση των λεπιών κατέστησε δυνατή την απόκτηση ενός βιοϋλικού με ιδιότητες κατάλληλες για χρήση στην αποκατάσταση του κερατοειδούς. Οι δοκιμές που πραγματοποιήθηκαν τόσο σε εργαστηριακές συνθήκες όσο και σε πειραματόζωα έδωσαν καλά λειτουργικά αποτελέσματα.
Χαμηλό κόστος και πιθανά οφέλη για τον αλιευτικό τομέα
Πέρα από το κλινικό ενδιαφέρον, οι ερευνητές επισημαίνουν ένα πρακτικό πλεονέκτημα: η προέλευση του υλικού το καθιστά φθηνό και εύκολο στην απόκτησή του. Τα λέπια των ψαριών είναι ένα υποπροϊόν της αλιευτικής βιομηχανίας που σε πολλές περιπτώσεις απλώς απορρίπτεται. Η μετατροπή του σε πρώτη ύλη για ιατρικά εμφυτεύματα ανοίγει μια πιθανή χρήση που θα μπορούσε να έχει θετικές οικονομικές συνέπειες.
"Το προϊόν αυτό είναι πολύ προσιτό, εύκολο στην απόκτηση και φθηνό, και θα μπορούσε να συμβάλει στην τόνωση του αλιευτικού τομέα σε μια περιοχή που πλήττεται από πολλούς περιορισμούς και κλιματικούς παράγοντες", εξηγεί η Ingrid Garzón, καθηγήτρια Ιστολογίας στο UGR και ερευνήτρια στο Ινστιτούτο Βιοϋγειονομικών Ερευνών ibs.GRANADA.
Η έρευνα χρηματοδοτήθηκε από το Instituto de Salud Carlos III, στο πλαίσιο του Υπουργείου Επιστημών, Καινοτομίας και Πανεπιστημίων, μέσω του έργου PI23/00335. Το έργο παρουσιάστηκε παρουσία του διευθυντή του νοσοκομείου Clínico San Cecilio de Granada, Manuel Reyes, γεγονός που αντανακλά το ενδιαφέρον του κλινικού περιβάλλοντος για την ανάπτυξη αυτής της ερευνητικής γραμμής.
Ο δρόμος προς τα εμπρός
Τα αποτελέσματα είναι προκαταρκτικά αλλά επαρκώς αξιόπιστα για να δικαιολογήσουν τη συνέχιση της έρευνας. Η εργαστηριακή φάση και οι δοκιμές σε ζώα έχουν περάσει τα πρώτα φίλτρα, αλλά πριν αυτό το είδος εμφυτεύματος φτάσει στο χειρουργείο είναι απαραίτητο να ολοκληρωθούν οι κλινικές δοκιμές σε ανθρώπους, μια διαδικασία που συνήθως διαρκεί χρόνια και απαιτεί αυστηρή ρύθμιση.
Αυτό που έχει καταφέρει μέχρι στιγμής η ομάδα της Γρανάδας είναι να αποδείξει ότι το υλικό λειτουργεί σε βιολογικό και δομικό επίπεδο. Το ότι τα λέπια κυπρίνου μπορούν να μετατραπούν σε βιώσιμο κερατοειδή δεν αποτελεί ακόμη κλινική πραγματικότητα, αλλά είναι μια υπόθεση που υποστηρίζεται από δεδομένα. Σε έναν τομέα όπου η έλλειψη δοτών παραμένει ένα πρόβλημα χωρίς εύκολη λύση, αυτό είναι αρκετά σημαντικό.